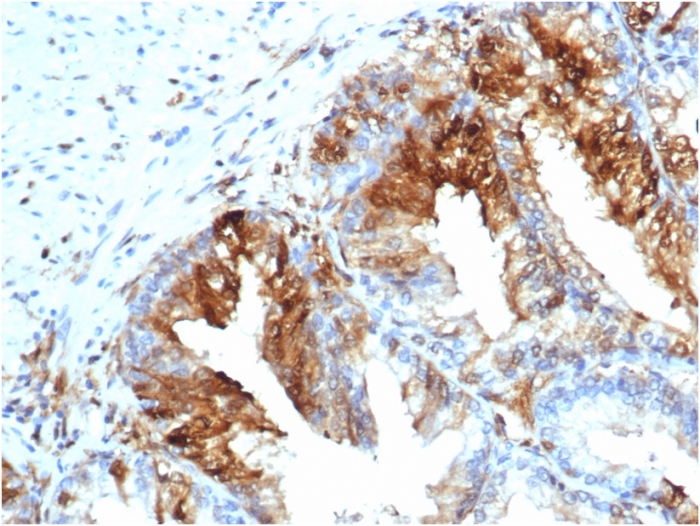

Formalin-fixed, paraffin-embedded human skeletal muscle stained with FABP5 Recombinant Mouse Monoclonal Antibody (rFABP5/6354).

Formalin-fixed, paraffin-embedded human esophagusstained with FABP5 Recombinant Mouse Monoclonal Antibody (rFABP5/6354).

SDS-PAGE Analysis of Purified FABP5 Recombinant Mouse Monoclonal Antibody (rFABP5/6354). Confirmation of Purity and Integrity of Antibody.

Western blot analysis of HeLa cell lysate using FABP5 Recombinant Mouse Monoclonal Antibody (rFABP5/6354).
This gene encodes the fatty acid binding protein found in epidermal cells, and was first identified as being upregulated in psoriasis tissue. Fatty acid binding proteins are a family of small, highly conserved, cytoplasmic proteins that bind long-chain fatty acids and other hydrophobic ligands. FABPs may play roles in fatty acid uptake, transport, and metabolism. Polymorphisms in this gene are associated with type 2 diabetes. The human genome contains many pseudogenes similar to this locus. FABP5 is also associated with poor survival in triple-negative breast cancer. Additionally, FABP5 gene is upregulated in colorectal cancer cells compared to normal colon cells in a manner that correlates with disease stage and that FABP5 significantly promotes colorectal cancer cell growth and metastatic potential.
There are no reviews yet.